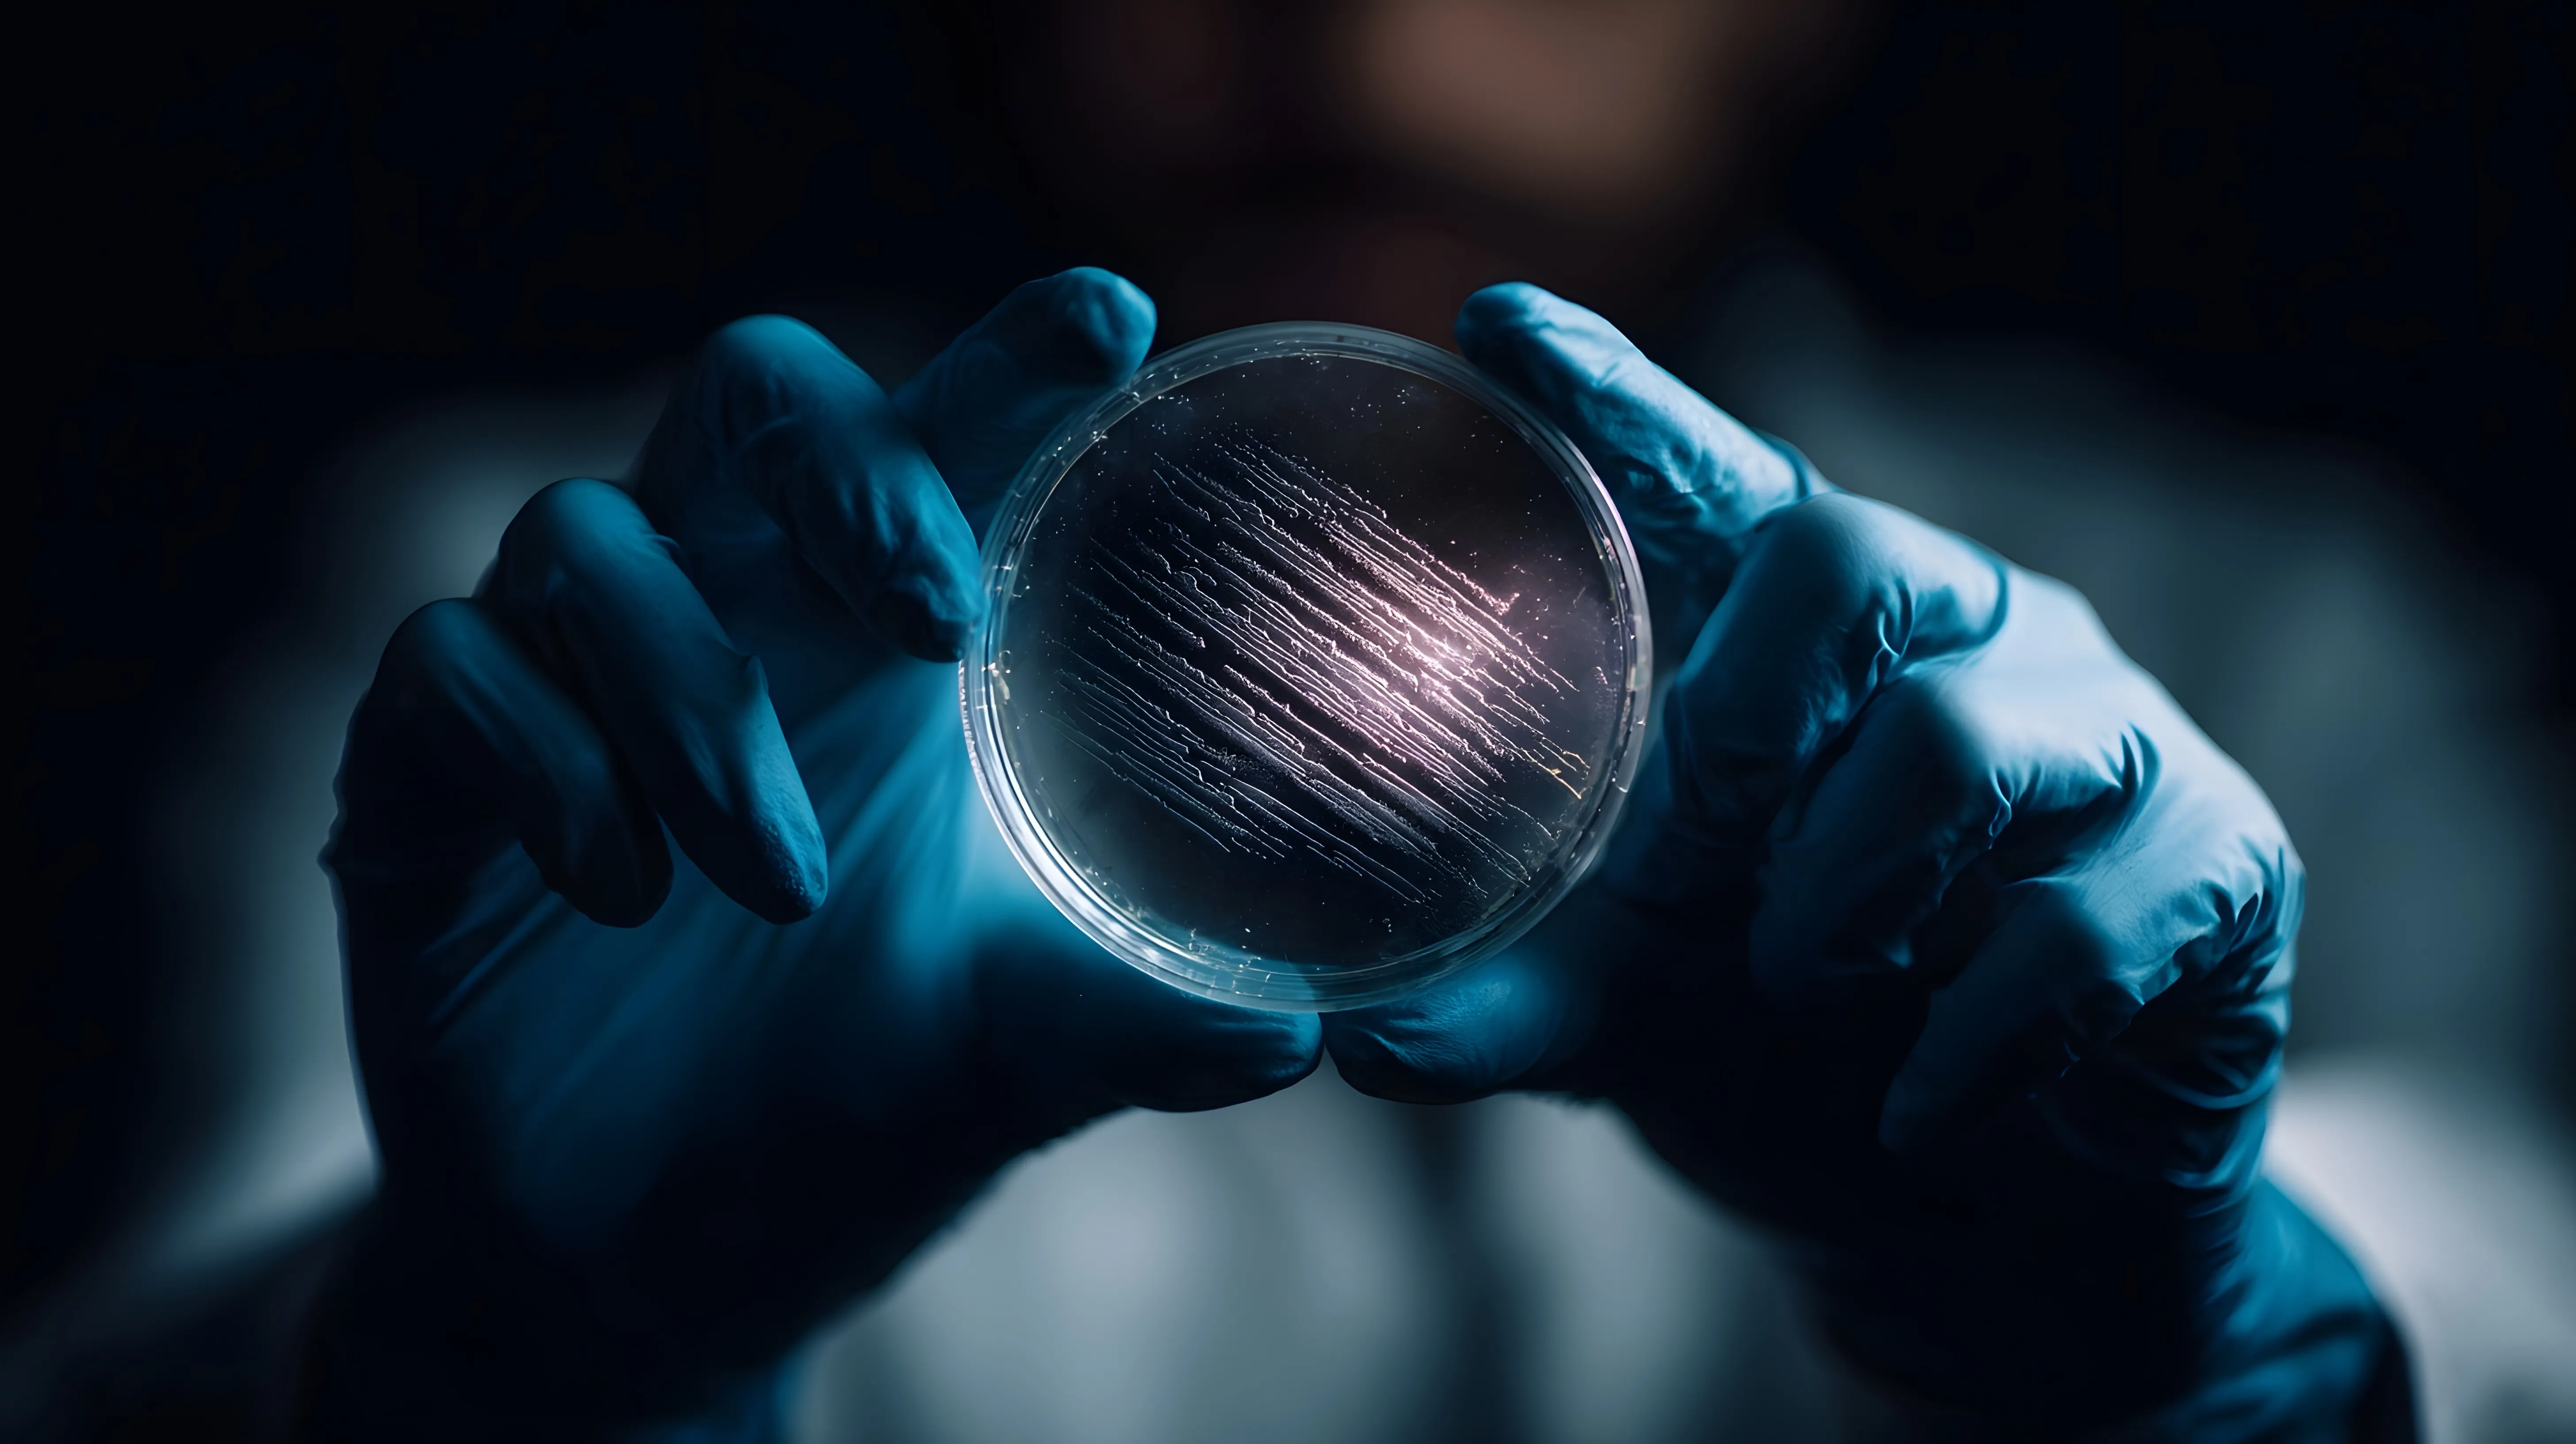

Intellectual Property
A Protected Technology Platform
Dakota's encapsulation technology is backed by a proprietary patent portfolio and trade secrets that create durable competitive advantages across multiple application categories.
Competitive Edge
Commercial Advantages
Six core advantages that differentiate Dakota's platform in the marketplace.
Validated to 40°C Accelerated Conditions
Validated to 40°C accelerated conditions, equivalent to a 36-month real-time shelf life. No cold chain required. Products maintain full probiotic viability at elevated temperatures, eliminating refrigeration costs, expanding distribution possibilities, and freeing consumers and patients from any reliance on refrigeration.
Triggered Release
Probiotics remain encapsulated until skin contact, ensuring targeted delivery exactly where therapeutic benefit is needed.
FDA-GRAS Ingredients
Formulated exclusively with phospholipids recognized as Generally Regarded As Safe, streamlining regulatory pathways for consumer and therapeutic products.
Dual-Action Delivery
The phospholipid bilayer itself provides skin barrier repair benefits while simultaneously delivering live probiotic payload -- two therapeutic mechanisms in one.
Scalable Manufacturing
The encapsulation process integrates into standard cosmetic and pharmaceutical manufacturing workflows without specialized equipment or facilities.
Patent-Protected Platform
A growing portfolio of proprietary patents and trade secrets protects the core technology, formulation methods, and application processes.
Strategic Position
Built to Defend, Designed to Scale
Dakota's intellectual property strategy extends beyond individual patents. The platform encompasses proprietary formulation knowledge, manufacturing process expertise, and application-specific trade secrets developed through years of R&D. This layered protection creates a competitive moat that grows deeper with each new application area and partnership engagement. For licensing and co-development partners, this means access to a defended technology position in a rapidly growing market.

Platform Benefits
What the Encapsulation Enables
Beyond stability -- the phospholipid bilayer platform unlocks capabilities that conventional probiotic delivery cannot match.
Extended Viability Window
Live probiotics remain metabolically active for 36+ months at room temperature, compared to weeks or months under refrigeration for conventional formulations.
Formulation Flexibility
The encapsulation is compatible with creams, serums, gels, powders, and oral formats -- enabling product development across cosmetic, therapeutic, and nutraceutical categories.
Strain Agnostic Platform
The vesicle system works with multiple probiotic strains, allowing custom formulations tailored to specific conditions, applications, or partner requirements.
Preservative Compatibility
Encapsulated probiotics survive contact with common cosmetic preservatives that would kill unprotected live bacteria, enabling standard product formulation practices. The encapsulation also eliminates common formulation barriers — water, for example, is lethal to unprotected live bacteria but poses no threat to encapsulated probiotics.
Put This Technology to Work
Explore how Dakota's platform translates into product development, custom formulations, and manufacturing-ready solutions.
Contact Our Team